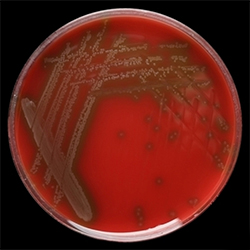

By Marcus A. Banks
Streptococcus pneumoniae is likely to be resistant to first-line antibiotics, particularly oral choices, according to Mayo Clinic researchers. Intravenous antibiotics are more effective at neutralizing the bacteria, which can cause sinusitis, severe sepsis and meningitis, researchers reported at the ASM Microbe 2025 meeting, in Los Angeles (Poster Session CPHM-P-201).
Pneumococcal conjugate vaccines, available since the 2000s, have been effective against antibiotic-resistant bacteria, but there’s always something of an arms race between bacteria and medications; in 2019, the CDC flagged antibiotic-resistant S. pneumoniae as a serious threat, the Mayo researchers noted. This prompted their analysis of the effectiveness of different antimicrobial agents.
Oral antibiotics are used more commonly in outpatient settings to combat pneumonia; and this study suggested they may be less effective—at least in vitro. The researchers tested various antibiotics against 6,591 S. pneumoniae blood culture isolates, determining minimum inhibitory concentrations using agar dilution and breakpoints from the Clinical & Laboratory Standards Institute. They determined which antibiotics S. pneumoniae had developed resistance to and which antibiotics were susceptible.
Resistance rates were erythromycin 38.5%, tetracycline 8.3% and trimethoprim-sulfamethoxazole (TMP-SMX) 8.9%. Blood cultures were 100% susceptible to linezolid, vancomycin, meropenem and levofloxacin.
Intravenous penicillin and ceftriaxone was less effective against meningitis, the researchers noted, supporting the use of empiric vancomycin therapy when someone may have meningitis.
“Non-susceptibility to several first-line antibiotics, especially oral antibiotics, remains a significant concern. Compared with intravenous drugs, we observed increased resistance among oral antibiotics (erythromycin, oral penicillin, tetracycline and TMP-SMX) that are preferred agents for outpatient management of Streptococcus pneumoniae infections,” the researchers said at ASM Microbe.
They called for continued antibiotic stewardship and vaccination to stem the spread of pneumococcal resistance.




